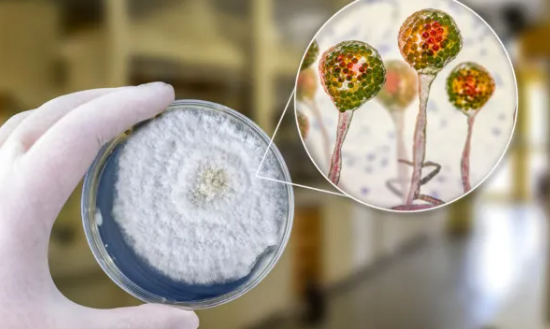
Pacientes com infecções fúngicas terão novas opções de tratamento pelo SUS

Pacientes com infecções fúngicas terão novas opções de tratamento pelo SUS
O Ministério da Saúde incorporou novos medicamentos no Sistema Único de Saúde (SUS) para o tratamento de pacientes imunocomprometidos e com infecções fúngicas. As novas tecnologias (Anidulafungina, Voriconazol e Isavuconazol), avaliadas e recomendadas pela Comissão Nacional de Incorporação de Tecnologias no Sistema Único de Saúde (Conitec), serão disponibilizadas nos próximos meses na rede pública.
Os pacientes imunocomprometidos são aqueles cujos mecanismos de defesa (sistema imunológico) estão comprometidos. É comum em pacientes oncológicos, soropositivos ou transplantados. Grupo considerado extremamente de risco são os pacientes com transplante recente de medula óssea. Até vírus brandos, que causam pequenas gripes, podem desencadear quadros mais graves, como pneumonias.
Fungos são um dos quatro grupos de organismos infecciosos, que incluem bactérias, vírus e parasitas. Infecções por fungos são as invasões dos tecidos por uma ou mais espécies e variam de superficiais, da pele, até mais profundas, de órgãos e do sangue (septicemia) ou doenças sistêmicas. Alguns fungos são oportunistas, afetam apenas pessoas imunodeprimidas. Outros são patogênicos, que adoecem o paciente independentemente do estado do seu sistema imunológico.
– Anidulafungina
Para tratamento de pacientes com candidemia e outras formas de candidíase invasiva. Trata-se de um agente antifúngico administrado na veia, que possui ação contra um amplo espectro de espécies do gênero Candida.
A candidíase engloba um conjunto de infecções que podem se manifestar tanto de forma localizada, como na boca e/ou faringe (candidíase orofaríngea), quanto de forma disseminada. Esta última inclui infecções de corrente sanguínea e de outros tecidos, como o sistema nervoso central, coração, olhos, ossos, peritônio (membrana que recobre a parede do abdômen e a superfície dos órgãos ali localizados), fígado e outros.
A cada ano, a candidíase invasiva afeta mais de 250 mil pessoas em todo o mundo e causa mais de 50 mil mortes. No Brasil, dados apontam para a ocorrência de 2,5 casos de candidemia para cada mil internações hospitalares. Estudo recente realizado no Paraná e publicado em 2021 verificou 2,7 casos de candidemia para cada mil pacientes por dia e 1,2 episódios para cada mil internações.
– Voriconazol
Para tratamento de pacientes com aspergilose invasiva, doença causada por espécies de fungos do gênero Aspergillus e que se manifesta nas vias aéreas e pulmões, podendo envolver outros órgãos, causando infecção do sistema nervoso central, do trato gastrointestinal, olhos, pele, revestimento interno do coração e até mesmo se disseminar por todo o organismo. Os sintomas incluem febre, calafrios, choque, delírio e coágulos sanguíneos. Pode ocorrer também dificuldade de respirar, insuficiência renal e do fígado (nesse caso, a pele e os olhos ficam amarelados devido ao mau funcionamento do órgão).
Estima-se que ocorram por ano no Brasil 12 casos de infecção invasiva por fungos do gênero Aspergillus para cada milhão de habitantes. O voriconazol é um agente que combate diversos tipos de fungos, sendo empregado no tratamento da aspergilose invasiva e de várias outras infecções fúngicas. Quanto mais cedo se inicia o tratamento melhores são as chances de recuperação.
– Isavuconazol
Para tratamento da fase de consolidação de pacientes diagnosticados com todas as formas de mucormicose. Essa é uma infecção rara, com alta taxas de letalidade, que afeta principalmente pessoas com imunidade comprometida, vítimas de traumas com perfuração de alguma parte do corpo, pessoas com alto índice de ferro no sangue, pacientes com diabetes ou câncer nas células sanguíneas ou que já tenham realizado transplante de órgãos.
O isavuconazol é um medicamento que age eliminando ou paralisando o crescimento de diversos tipos de fungos, incluindo os da ordem Mucorales. É indicado para tratamento da mucormicose e da aspergilose invasiva.
O tratamento da mucormicose consiste em administração imediata de medicamentos antifúngicos, composta por duas fases: a de indução (ataque) e a de consolidação (manutenção). A fase de indução dura em média 4 semanas e o medicamento indicado é a anfotericina B. A depender das condições clínicas do paciente, podem ser recomendadas cirurgias para remoção dos tecidos que foram atingidos pelo fungo.
A fase de consolidação se caracteriza por um período de manutenção do tratamento, quando existe o controle da doença e tem duração média de aproximadamente seis meses. Nessa fase, apesar de ser possível continuar o tratamento com anfotericina B, o isavuconazol é o tratamento recomendado.
*Redação
Foto: Kateryna Kon/Shutterstock






